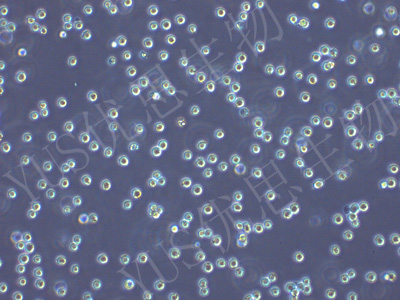

产品中心
产品中心
-

NCI-H209 人小细胞肺癌细胞(STR鉴定)
货号:YLH001规格: 1*10^6 -

PC-3 人前列腺癌细胞(STR鉴定)
货号:YLH002规格: 1*10^6 -

GBC-SD 人胆囊癌细胞(STR鉴定)
货号:YLH003规格: 1*10^6 -

MCF-10A 人乳腺上皮细胞(STR鉴定)
货号:YLH004规格: 1*10^6 -

MDA-MB-231 人乳腺癌细胞(STR鉴定)
货号:YLH005规格: 1*10^6 -
RS4:11 人急性淋巴白血病细胞(STR鉴定)
货号:YLH006规格: 1*10^6 -

VCAP 人前列腺癌细胞(STR鉴定)
货号:YLH007规格: 1*10^6 -

OE19 人食管癌细胞(STR鉴定)
货号:YLH008规格: 1*10^6 -

BT-B 人宫颈癌细胞(STR鉴定)
货号:YLH010规格: 1*10^6 -

NCI-H460 人大细胞肺癌细胞(STR鉴定)
货号:YLH011规格: 1*10^6 -

SNU-182 人肝癌细胞(STR鉴定)
货号:YLH012规格: 1*10^6 -

CA SKI 人宫颈癌肠转移细胞/人宫颈癌上皮细胞(STR鉴定)
货号:YLH013规格: 1*10^6
在线咨询
Online consultation

关注微信公众号


